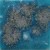
Image 1

Loading... Please wait...
Loading... Please wait...免運費額:港島/新界 $1500 沙田及荃葵青 $1200 九龍 $1000 心陶自提點 $600
- Home
- Glaze
- Low-Fire Glaze
- Mayco Crystalities - S-2711 Tahiti Grape (4oz)
Categories
Our Newsletter
Mayco Crystalities - S-2711 Tahiti Grape (4oz)
Product Description

Cone 06: Tahiti Grape is a semi-opaque blue base glaze with gray and white crystals that melt/bloom and black specks.
Cone 6: Base glaze fades – crystals fade and melt; speckles remain. Enhanced mobility. Surface issues may occur.
Safety Warning
Finishedware producers may be required to have their ware food safe tested prior to introducing into commerce.

You Recently Viewed...
New Products
-
$880.00

-
$168.00

-
$168.00

-
$168.00

-
$940.00